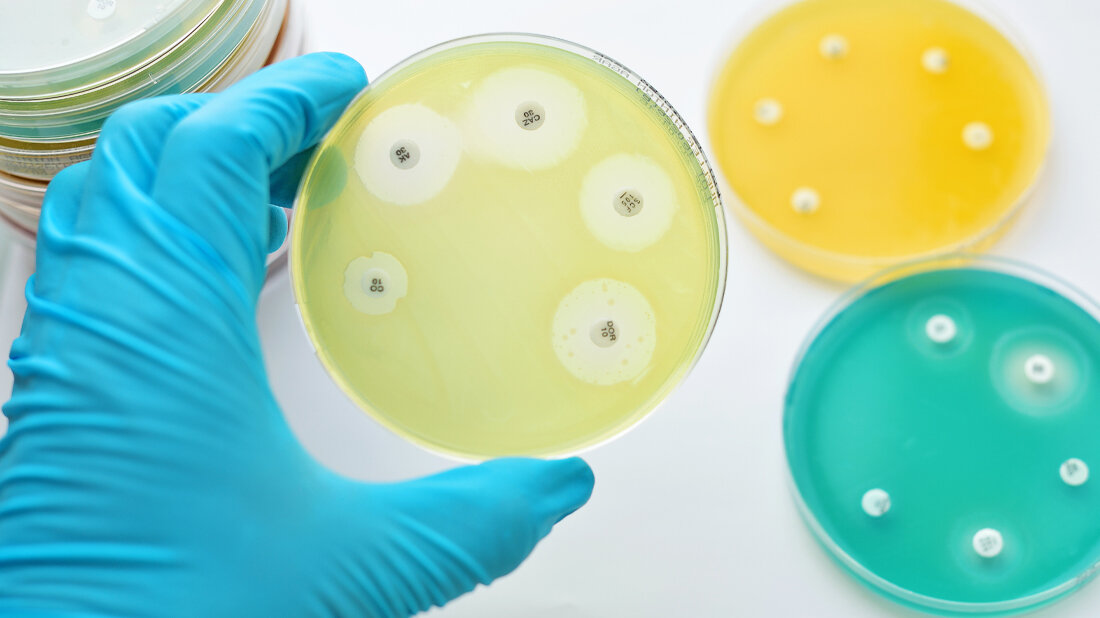
Antibiotikaresistenzen

Antibiotikaresistenzen verhindern
Antibiotikaresistenzen sind in der Medizin ein großes Thema. Neueste Forschungsergebnisse des Max-Planck-Instituts für Evolutionsbiologie in Plön (MPI) legen nun nahe, dass ein schneller Wechsel von Antibiotika während der Behandlung eines Patienten einer eventuellen Resistenzevolution erfolgreich entgegenwirken könnte. Die optimale Geschwindigkeit der Wechsel hängt jedoch von verschiedenen Faktoren ab. Dazu gehöre unter anderem die Wechselwirkung zwischen den Medikamenten.
Medikamentenpaare, die kollateral sensitiv sind
Experimente zeigen, dass schnelle Wechsel zwischen Antibiotika die Ausbreitung von Resistenzen verhindern können. Besonders geeignet für solche Therapien könnten Medikamentenpaare sein, die kollateral sensitiv sind. Das heißt, dass eine Resistenz gegenüber dem einen Medikament dazu führt, dass die Bakterien empfindlicher gegenüber dem anderen Medikament werden. Allerdings unterscheiden sich die Umgebungsbedingungen der Bakterien im Patienten klar von denen in einem Labor. Ein wichtiger Unterschied dabei ist, dass die Medikamente im Labor abrupt gewechselt werden können, während bei den Patienten natürliche Abbauprozesse zu schwankenden Antibiotika-Konzentrationen führen. Dabei kann es Phasen geben, in denen sich die Dosen aufeinanderfolgender Medikamentengaben überlagern. Während solcher Überschneidungsphasen könnten Wechselwirkungen zwischen den Medikamenten die Evolutionsdynamik beeinflussen.
Zwei mathematische Modelle zum Vergleich
Um die Lücke zwischen dem Labor und einer möglichen klinischen Anwendung zu schließen, haben die Doktorandin Christin Nyhoegen und die Forschungsgruppenleiterin Dr. Hildegard Uecker der Forschungsgruppe Stochastische Evolutionäre Dynamik des MPI in Plön zwei mathematische Modelle zum Vergleich aufgestellt - ein „Labormodell“ und ein pharmakokinetisch-pharmakodynamisches „Patientenmodell“. Die Analyse zeige, dass im Labor die Behandlung mit dem schnellsten Wechsel der Medikamente die Bakterienpopulation immer mindestens genauso gut unterdrücke, wie Behandlungen mit langsameren Wechseln. Bei der Behandlung von Patienten treffe das zwar häufig auch zu, manchmal könne jedoch ein etwas langsamerer Wechsel vorteilhaft sein. Das vor allem dann, wenn die Bakterien langsam replizieren und die pharmakodynamische Kurve steil ist oder die Medikamente antagonistisch wechselwirken. „Unsere Ergebnisse zeigen, dass sequentielle Therapie nicht nur im Labor, sondern auch im Patienten gut funktionieren könnte. Die optimale Strategie kann aber unter Umständen leicht variieren“, sagt die Doktorandin Christin Nyhoegen.
Grundlage für klinische Studien?
Wenn vor der Behandlung keine Resistenzen vorhanden sind, bringe die kollaterale Sensitivität keinen wesentlichen Vorteil, es sei denn, die Zellteilungsrate sei niedrig und der Wechsel zwischen den Medikamenten langsam. Im Gegensatz dazu haben Wechselwirkungen zwischen den Medikamenten einen großen Einfluss auf die Effizienz von Behandlungen, in denen schnell gewechselt wird. Das zeige, wie wichtig diese für die optimale Auswahl von Medikamentenpaaren sein könnten.
Unabhängig von der theoretischen Studie gibt es erste Bemühungen, mittels Beobachtungsstudien Hinweise auf die Wirksamkeit der sequentiellen Therapie im Patienten zu erlangen. Ergebnisse dieser als auch der theoretischen Studie könnten eine Grundlage für die Planung randomisierter klinischer Studien bieten, die derzeit jedoch noch nicht umsetzbar sind.
Quelle: idw/Max-Planck-Institut für Evolutionsbiologie
Artikel teilen